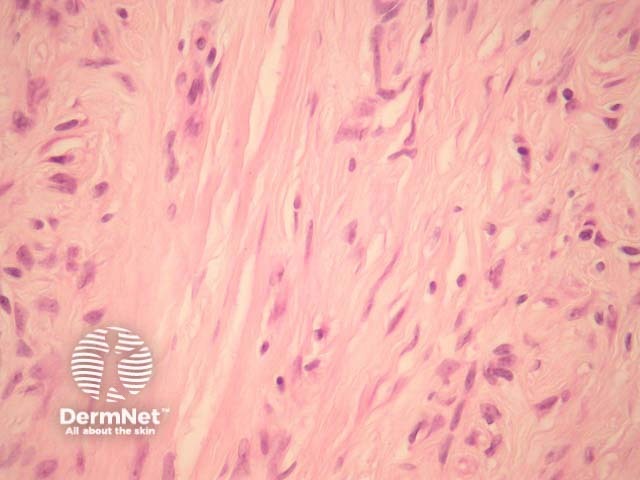
Figure 1
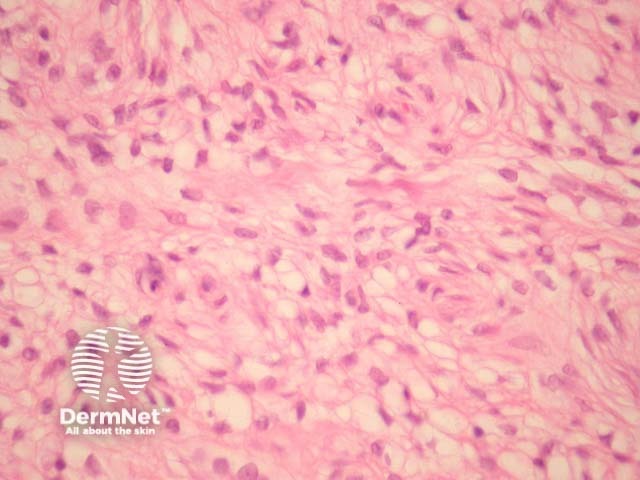
Figure 2

Main menu
Common skin conditions
NEWS
Join DermNet PRO
Read more
Quick links
Author: Assoc Prof Patrick Emanuel, Dermatopathologist, Auckland, New Zealand, 2013.
Perineurioma is an uncommon benign peripheral nerve sheath tumour composed exclusively of perineural cells.
Perineurioma tumour cells are spindle shaped, with long delicate cell processes amidst a collagenous stroma (figure 1). The spindle cells have pale open nuclei with a delicate chromatin pattern, an inconspicuous eosinophilic nucleolus and indistinct cell borders (figures 1, 2). Myxoid change may be seen and can cause diagnostic confusion (figure 3). Whorls of cells are often seen which are reminiscent of meningioma (figure 4, arrows).
Figure 1
Figure 2

Figure 3

Figure 4
Immunohistochemical studies show membranous positivity with EMA.
The tumour cells are negative for S100 protein, cytokeratin, desmin and smooth muscle actin.
Dermatofibroma – Typically show polymorphous cell population with more prominent inflammatory cells and often contains multinucleate giant cells. These are EMA negative.
Neurothekeoma – These tumours display a characteristic lobular or nested growth pattern. These are consistently negative with EMA.
Neurofibroma – Neurofibromas are positive with S100 and are composed of other components of peripheral nerves (not just perineural cells).